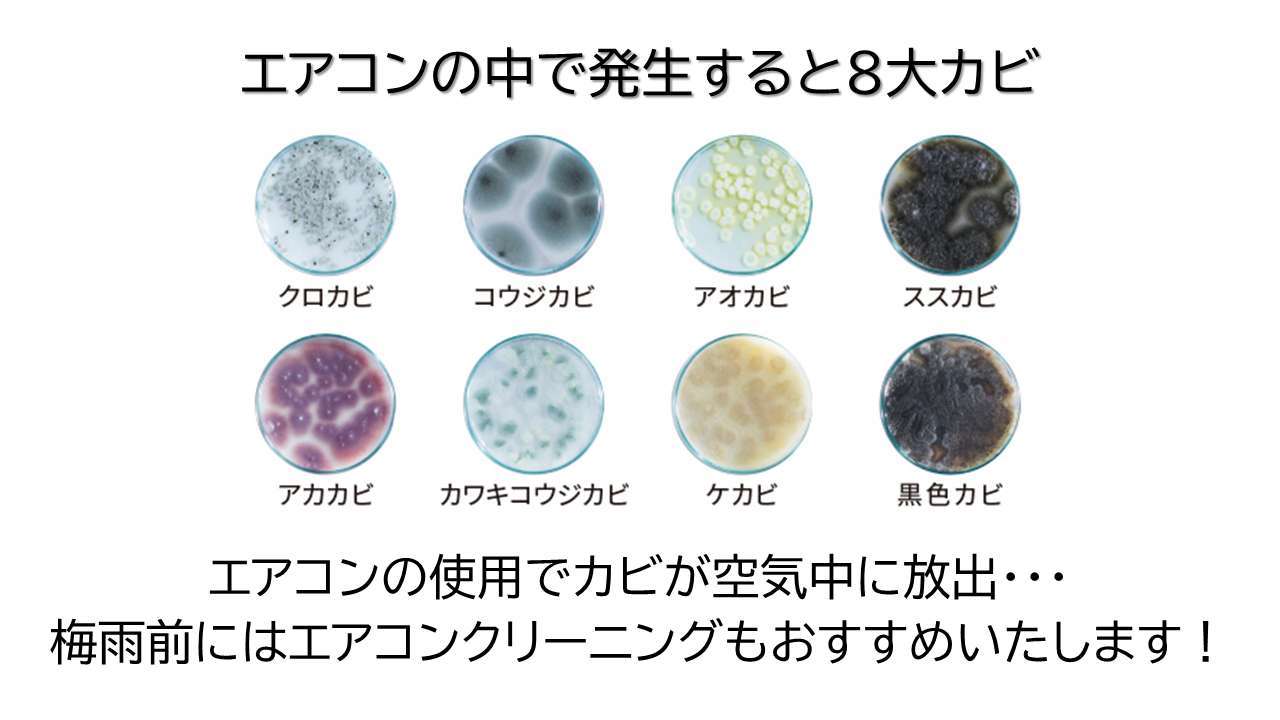

皆さんこんにちは。
茨城県水戸市を拠点に、笠間市、ひたちなか市、日立市など茨城県内でハウスクリーニングや定期清掃、おうちのウイルス対策のバリアコーディングを手掛ける株式会社アンツです。
しっかり掃除をしていても、少しでも気を許すと壁や床などいたるところに発生するのがカビです。「生えてくるものは仕方ない」と、なかば諦めていませんか?カビは見た目の悪さだけでなく、家族に健康被害を引き起こす原因にもなります。今回は、大人よりも免疫力の弱い子どもたちの健康を考え、カビによる影響や気を付けて掃除すべき場所についてご紹介します。
■カビが家庭や子どもに及ぼす影響
日本の梅雨時は空気中のカビの量が冬の5〜6倍となります。カーペットよりも掃除がしやすく清潔を保てる、フローリングの部屋でも同じです。たくさんの胞子が空気中を飛び回ると、食べ物はもちろん壁や床などにもカビが発生します。カビの粒子は花粉よりも細かく、人間の口や鼻、そして傷口や乾燥した肌などあらゆるところから体内に侵入し、感染症やアレルギーを起こす原因となるのです。免疫力が低い人は感染しやすく、健康な人でもアレルギー発症の可能性があります。特に免疫力が低い3歳くらいまでのお子さんを持つ家庭では、ぜんそくやアトピーになるリスクを避けてあげたいですよね。

■カビ、雑菌がはびこる床に最も近いのは子どもたち
子どもがいるご家庭で、最も清潔さを保ちたい場所は床です。赤ちゃんはフローリングの床の上をハイハイし、幼児は床に座ったままおもちゃで遊びます。大人と違い、子どもたちは床から数cm~数十cmという世界で過ごしているのです。フローリングには、ホコリや髪の毛に加え、粒子の小さいカビや花粉、ハウスダスト、食べこぼしの油や手肌の皮脂などの汚れがあります。想像よりはるかに床の菌の影響を受けやすい環境で暮らす子どもたちのために、床は特に意識して掃除しなくてはいけません。

■化学製品ゼロ使用の洗剤で清潔・健康に!

床だけに限らず、小さな子どもが過ごす家はどこも清潔にしておきたいものです。しかし、共働き家庭も多く忙しい毎日の中、家の隅々まで掃除するのは時間的にも体力的にも厳しいですよね。また、目に見えない菌へどう対処すればいいか、お困りの方も多いのではないでしょうか。そんな時は、プロに頼るのもひとつの方法です。まだ免疫力の低い子どもたちのために、化学製品を使用しないハウスクリーニング業者にお掃除を任せて、安心を手に入れませんか?
茨城県水戸市を拠点にハウスクリーニングを行っているアンツは、暮らす人の健康、そして、持続可能な自然環境を考え、化学製品を一切使わず、電解水で清掃を行います。カビ対策、A型インフルエンザ、新型コロナウイルス対策の光触媒によるバリアコーティングも可能です。
清潔・健康を求めてハウスクリーニングをご検討中の方、ご興味のある方は、ぜひアンツまでお気軽にご連絡ください!
アンツの施工事例はこちらをご覧ください👇


